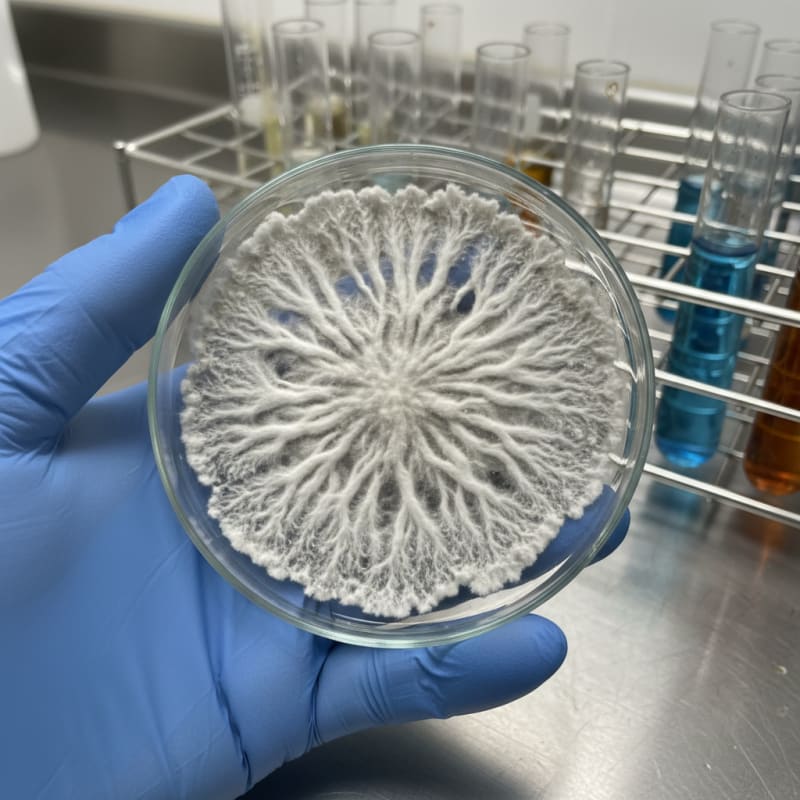
Microdosing illustration 3

Psilocybin Use: Two Worlds of Dosing
Quick Summary
New data shows millions of people are microdosing psilocybin, a practice far more common than the high-dose clinical trials that dominate media headlines. This highlights a major disconnect between regulated research, which focuses on intense therapeutic sessions, and real-world use, which favors small, repeated doses for wellness. This divergence shapes public understanding, policy, and product development.

A recent 2026 report from the RAND Corporation has illuminated a stark reality in the world of psychedelics: the way people actually use psilocybin is dramatically different from how it is studied in clinical trials. The data reveals that an estimated 10 million U.S. adults are microdosing, a practice that now accounts for nearly half of all psilocybin use days. While headlines often focus on high-dose, clinically supervised sessions for treating major depression or addiction, the data shows a quiet, parallel reality where millions of people integrate sub-perceptual doses into their regular wellness routines. This divergence between clinical research and real-world behaviour creates two distinct narratives about what psilocybin is for and how it should be used.
This isn't a minor footnote in the story of psilocybin; it is the story. The numbers suggest that for every individual undergoing a profound, high-dose therapeutic journey in a clinical setting, there are thousands managing their wellness with small, repeated doses at home. This consumer-led trend has evolved faster than research and regulation can keep up, shaping a marketplace that caters directly to the preference for low-dose, consistent, and accessible products.
What Does the New Data Reveal About Psilocybin Use?
The RAND study provides the clearest picture yet of psychedelic consumption patterns. Among its key findings is that psilocybin is the most commonly used classic psychedelic, with 11 million adults reporting use in the past year. More importantly, it quantifies the dominance of microdosing. According to the research:
Majority Practice: Approximately two-thirds of individuals who used psilocybin in the last year reported microdosing at least once. Significant Volume: Of the more than 200 million days of psilocybin use reported, nearly half involved microdosing.
Researchers defined microdosing as "taking a fraction of a regular dose that’s much lower than what you take if you were intending to trip or hallucinate." This finding confirms what many in the industry have long observed anecdotally: most people aren't seeking a transformative psychedelic experience every time they use mushrooms. Instead, they are engaging in a measured, intentional practice for more subtle benefits, such as improved mood, enhanced creativity, or greater focus. The fact that this behaviour has become so widespread without formal guidance from medical bodies highlights a powerful, user-driven movement in wellness.
Why Is Most Research Focused on High Doses?
Despite the prevalence of microdosing, the vast majority of well-funded, FDA-approved clinical research investigates the effects of single, large doses of psilocybin. Studies exploring psilocybin for smoking cessation or Major Depressive Disorder (MDD) typically involve one or two sessions with doses ranging from 25mg to 35mg of pure psilocybin, enough to induce a powerful, multi-hour psychedelic experience.
The rationale behind this high-dose model is based on a specific therapeutic hypothesis. Researchers believe the "mystical" or "peak" experience is a primary driver of long-term therapeutic change. By profoundly altering a person's state of consciousness, the experience can help break rigid patterns of thought and behaviour associated with conditions like addiction and depression. This model is also more compatible with the structure of traditional pharmaceutical trials, which are designed to measure a drug's dramatic effect against a placebo after a specific intervention.
Measuring the subtle, cumulative effects of microdosing is far more challenging. A true microdose is sub-perceptual, meaning it does not produce noticeable psychedelic effects. As a result, it's difficult to design a placebo-controlled trial where participants can't guess whether they received the active substance. For a deeper dive into this specific challenge, see our post on why science overlooks microdosing. This methodological difficulty is a key reason why high-dose studies attract more funding and regulatory attention, leaving the most common form of psilocybin use largely in the realm of anecdotal reports and observational data.
How Does This Disconnect Impact Consumers?
The gap between the clinical narrative and real-world use has several important consequences for the average person interested in psilocybin.
First, it skews public perception. Media coverage tends to polarize between portraying psilocybin as a miracle cure for severe mental illness or, as some outlets have framed it, an "alarming trend" of unregulated drug use. The mundane reality of a professional taking a microdose capsule with their morning coffee for improved focus doesn't make for a dramatic headline, but it is far closer to the typical use case.
Second, it highlights the importance of product design. The market has responded not to clinical trial data, but to consumer demand. The rise of precisely dosed edibles, especially capsules, is a direct result of the microdosing phenomenon. A product like our Core Microdose Capsules, which contain a consistent 250mg dose of *Psilocybe cubensis, is designed to eliminate the guesswork and variability of using raw, dried mushrooms. Consumers seeking consistency for a weekly or daily regimen have driven the demand for products that offer reliability above all else. You can find a variety of these in our online shop.
What Does "Microdosing" Mean in Practice?
Because it has evolved outside of clinical research, there is no universally agreed-upon standard for what constitutes a microdose. It is generally understood to be between 1/10th and 1/20th of a recreational dose. The goal is to find the "sub-threshold" or "sub-perceptual" level that delivers benefits without interfering with daily functioning. For most people, this falls in the range of 50mg to 250mg of dried *Psilocybe cubensis mushrooms.
To manage dosage and tolerance, users often adopt specific protocols. These schedules involve taking a microdose on certain days and taking breaks on others. To learn more about the specifics of these popular regimens, our complete microdosing schedule guide offers a detailed breakdown. Formulations have also emerged to meet the goals of these protocols. For instance, our Focus Microdose Capsules are based on a popular stacking formula, combining 100mg of psilocybin with Lion's Mane mushroom and Niacin, tailored for those seeking cognitive enhancement.
The ongoing divergence between formal research and consumer-led wellness practices is a defining feature of the modern psychedelic landscape. As clinical trials continue to explore the power of high-dose therapy under medical supervision, the data shows that millions of users are forging a different path, integrating small, managed doses into their lives in a quiet but significant wellness revolution.
ShroomDash Editorial Team
Published 2026-03-14 · 5 min read read · Dosing



